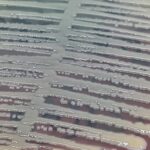
Klebsiella aerogenes -Introduction, Morphology, Pathogenicity, Lab Diagnosis, Treatment, Prevention, and Keynotes

Tag: Rod-shaped
Klebsiella aerogenes : Introduction, Morphology, Pathogenicity, Lab Diagnosis, Treatment, Prevention, and Keynotes
Introduction Klebsiella aerogenes (formerly Enterobacter aerogenes) is an opportunistic Gram-negative, facultative anaerobic bacterium....
Introduction Klebsiella aerogenes (formerly Enterobacter aerogenes) is an opportunistic Gram-negative, facultative anaerobic bacterium....
Pseudomonas fluorescens- Introduction, Morphology, Pathogenicity, Lab Diagnosis, Treatment, Prevention, and Keynotes
 Introduction Pseudomonas fluorescens is a Gram-negative bacterium that lives in...
Introduction Pseudomonas fluorescens is a Gram-negative bacterium that lives in...
Proteus penneri– Introduction, Morphology, Pathogenicity, Lab Diagnosis, Treatment, Prevention, and Keynote
 Introduction Proteus penneri is a Gram-negative bacterium primarily found in...
Introduction Proteus penneri is a Gram-negative bacterium primarily found in...
